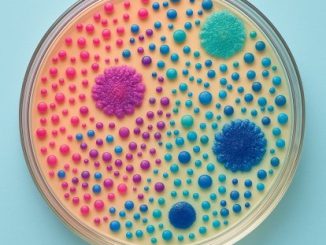
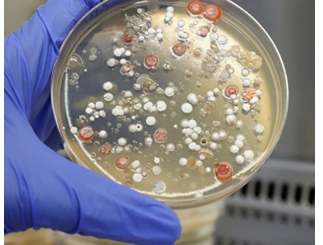

२४-०९-२०२५ | सूक्ष्मजीवांच्या तंदरुस्तीचे रहस्य !
सूक्ष्मजीवांच्या रंगीबेरंगी जगाला चैतन्य देणारा अदृश्य शिल्पकार म्हणजे पोषणमाध्यम. माणसाच्या संतुलित आहाराप्रमाणेच, त्यांच्या अन्न, पाणी आणि निवासाचं अचूक वैज्ञानिक मिश्रण. या पोषणमाध्यमामध्ये कार्बन(C), नायट्रोजन(N), खनिजे, पाणी, योग्य आम्ल-अल्कली व क्षारांचे संतुलन, जीवनसत्त्वे, अमिनो आम्ले, विविध […]